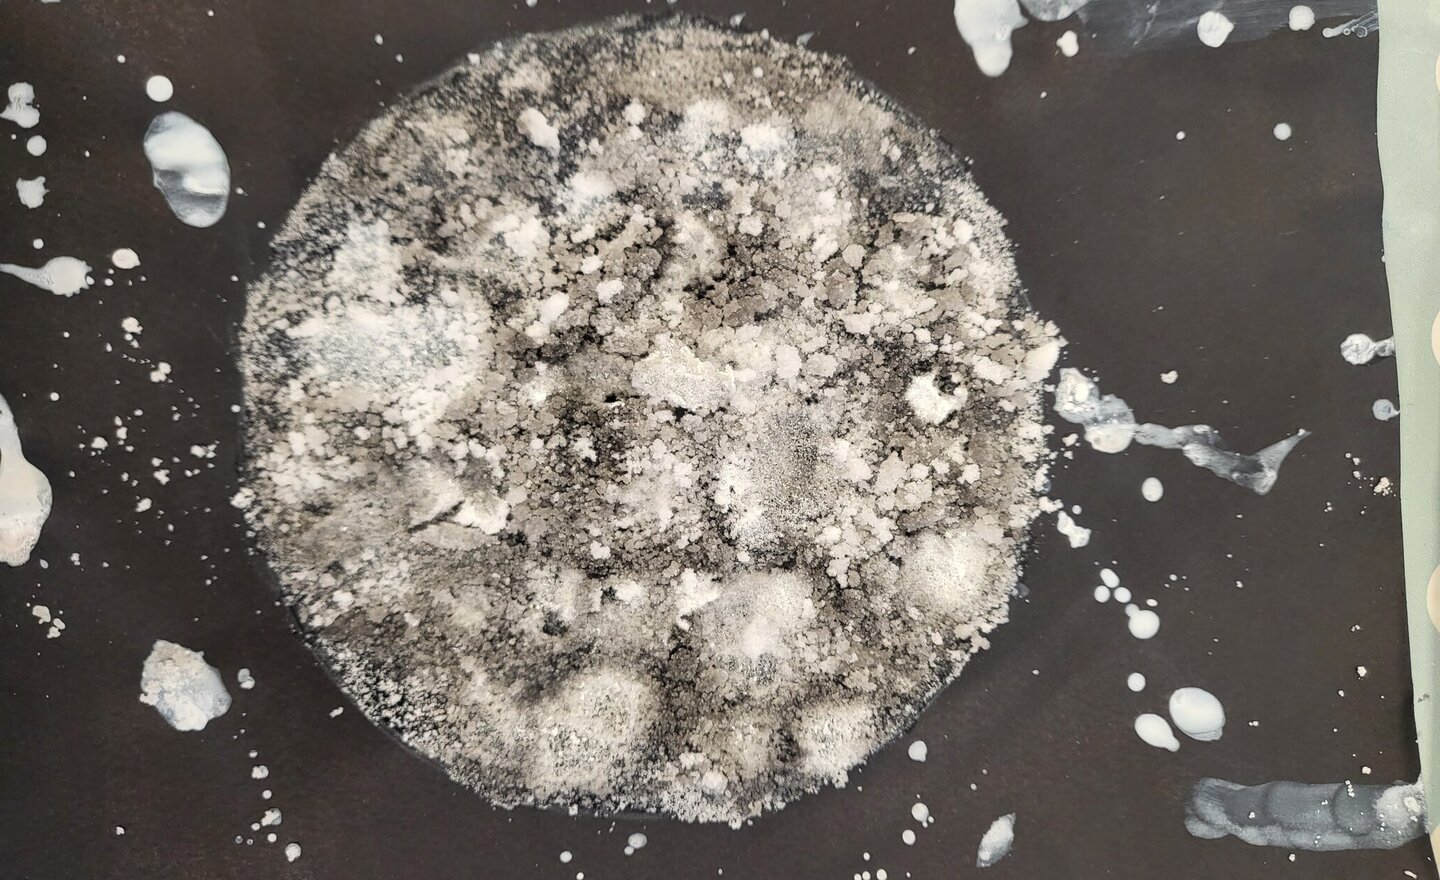
Image of Making the Moon

Making the Moon
We have been looking at space in Art and made moons out of paint and salt.
Paper Mache
Cross fell are making paper Mache hot air balloons. This ties in with the transport topic they are learning. We had allot of fun.
Christmas Market
If anyone is having a clear out in readiness for Christmas and has any bits that would be good for a tombola, teddy tombola, raffle or just any toys and books that are no longer required we would love to have any donations as we look ahead to our Christmas fair on the 3rd of December.
Thankyou in…
Save the date! Fireside Nativity coming soon
We are very much looking forward to welcoming families to school for our APS Christmas production on Wednesday 10th December
✨Fireside Nativity✨
There will be 2 performances one at 2.15pm and another at 6pm
Do save the date our rehearsals are in full swing and we are sure your children…
Anti- bullying week - odd socks day
Anti-Bullying Week - odd sock day / wear your jumper backwards
Wednesday 12th November
The School Council have organised Odd Socks Day which is a light-hearted but powerful way for pupils and staff to mark Anti‑Bullying Week by wearing odd socks. It’s a simple, fun way to celebrate what…
A moment of remembrance
Today Cross Fell took part in some activities to mark remembrance day
Seasonal changes
We had a really super afternoon learning all about seasonal changes and painted our own seasonal trees. Great work everyone!
Forest school
Forest School today was about Remembrance Day and bonfire night. We talked with Anna about the red and purple poppies and what they meant and some children chose to make their own out of wood slices or clay. We did a poppy themed treasure hunt but the best part was getting to make a chocolate…
Gustav Klimt dress
Cross Fell have printed and constructed this dress inspired by Gustav Klimt.
1 minute maths!
Designed for use both in class and at home, White Rose's 1-minute maths app helps children build greater number confidence and fluency. It’s all about targeted practice in engaging, one-minute chunks!
It comes highly recommended from both the Cross Fell team and also the children who have…
Extra phonics support for our families
In school we are lucky enough to have access to a fantastic resource that allows us to share clips with our families that can be used to back up the learning that we are doing in school by providing extra practise in the form of fun videos that can be used at home.
Keep and eye out for links…
Making predictions
In English today, we challenged the children to make predictions about what happens next in our class story.
We learnt that a prediction is a clever guess or idea.
Here are some of our fantastic predictions, let’s see if any were correct on Monday.